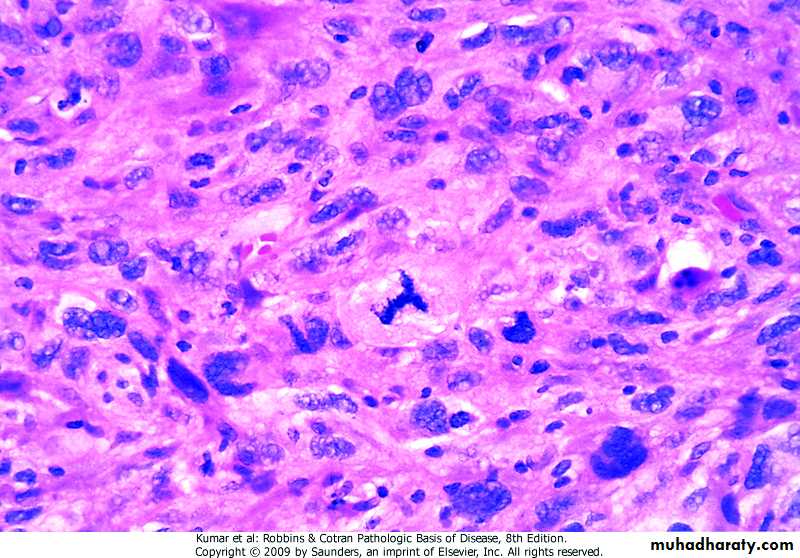

CHARACTERISTICS OF BENIGN AND MALIGNANT TUMORS
.benign & malignant tumors can be distinguished on the basis of -differentiation & anaplasia -rate of growth -local invasion -metastasisDifferentiation
.extent to which neoplastic cells resemble comparable normal cells both morphologically & functionally-benign tumors are always well differentiated
Thyroid, adenoma
Leiomyoma
-malignant tumors .well differentiated .moderately differentiated .poorly differentiated .undifferentiated (anaplastic)
Adenocarcinoma, well differentiated
Squamous cell carcinoma, well differentiated
Anaplasia
.characterized by• -marked pleomorphism (variation in size & shape of cells & nuclei)
• -marked abnormal nuclear morphology (enlarged nuclei, prominent nucleolie, coarse chromatin, hyperchromasia)
• -mitoses (especially abnormal)
• -loss of cell polarity
• -other changes (tumor giant cells,
• necrosis)
Undifferentiated (anaplastic ) Neoplasm
Undifferentiated Neoplasm
Dysplasia.encountered principally in epithelia.characterized by disordered growth -cellular atypia (pleomorphism, large hyperchromatic nuclei, high nucleo- cytoplasmic ratio) -architectural atypia (disorganized cells)
Carcinoma In Situ (CIS).dysplasia involving entire thickness of epithelium & remains confined by basement membrane
Carcinoma In Situ
Rate of Growth
.cell must undergo 30 population doublings to produce 109 cells (1gm), smallest clinically detectable mass.ten further doubling cycles to produce 1012 cells (1kgm), maximal size compatible with life
.rate of tumor growth is determined by
-doubling time of tumor cells
-fraction of tumor cells in proliferation
-rate of cell loss
-level of tumor differentiation
.proportion of cells within a tumor in proliferative pool is called growth fraction.during early, submicroscopic phase of tumor growth, most cells are in proliferative pool .in clinically detectable tumor, growth fraction is only 20% or less
Tumor cells leaving replicative pool by reversion to G0, differentiation, & death
Cancer Stem Cells and Cancer Cell Lineages
.cancers are immortal & have limitless proliferative capacity [contain cells with “stem cell-like” properties (tumor- initiating cells-T-IC) forming 0.1%-25% of tumor cells]Local Invasionbenign tumors .nearly all benign tumors -grow as cohesive expansile masses surrounded by rim of compressed fibrous tissue (pseudocapsule or capsule) -remain localized to their site of origin -do not have the capacity to infiltrate, invade, or metastasize
Breast, fibroadenoma
Breast, fibroadenoma
malignant tumors .cancers -infiltrate, invade, & destroy adjacent tissue -are poorly demarcated from adjacent normal tissue
Breast, invasive duct carcinoma
Breast, invasive duct carcinoma
Metastases
.a feature of malignant tumor, defined as tumor implants discontinuous with the primary tumor.pathways of spread
• -seeding of body cavities or surfaces
Peritoneum, seeding surface
• -lymphatics (carcinomas) .sentinel lymph node is the first node in a regional lymphatic basin that receives lymph from primary tumor
Lymph node, lymphatic spread
-hematogenous (sarcomas) .arteries, with their thicker walls, are less readily penetrated than are veins .with venous invasion, tumor cells rest in the first capillary bed they encounter (liver & lungs are mostly involved)